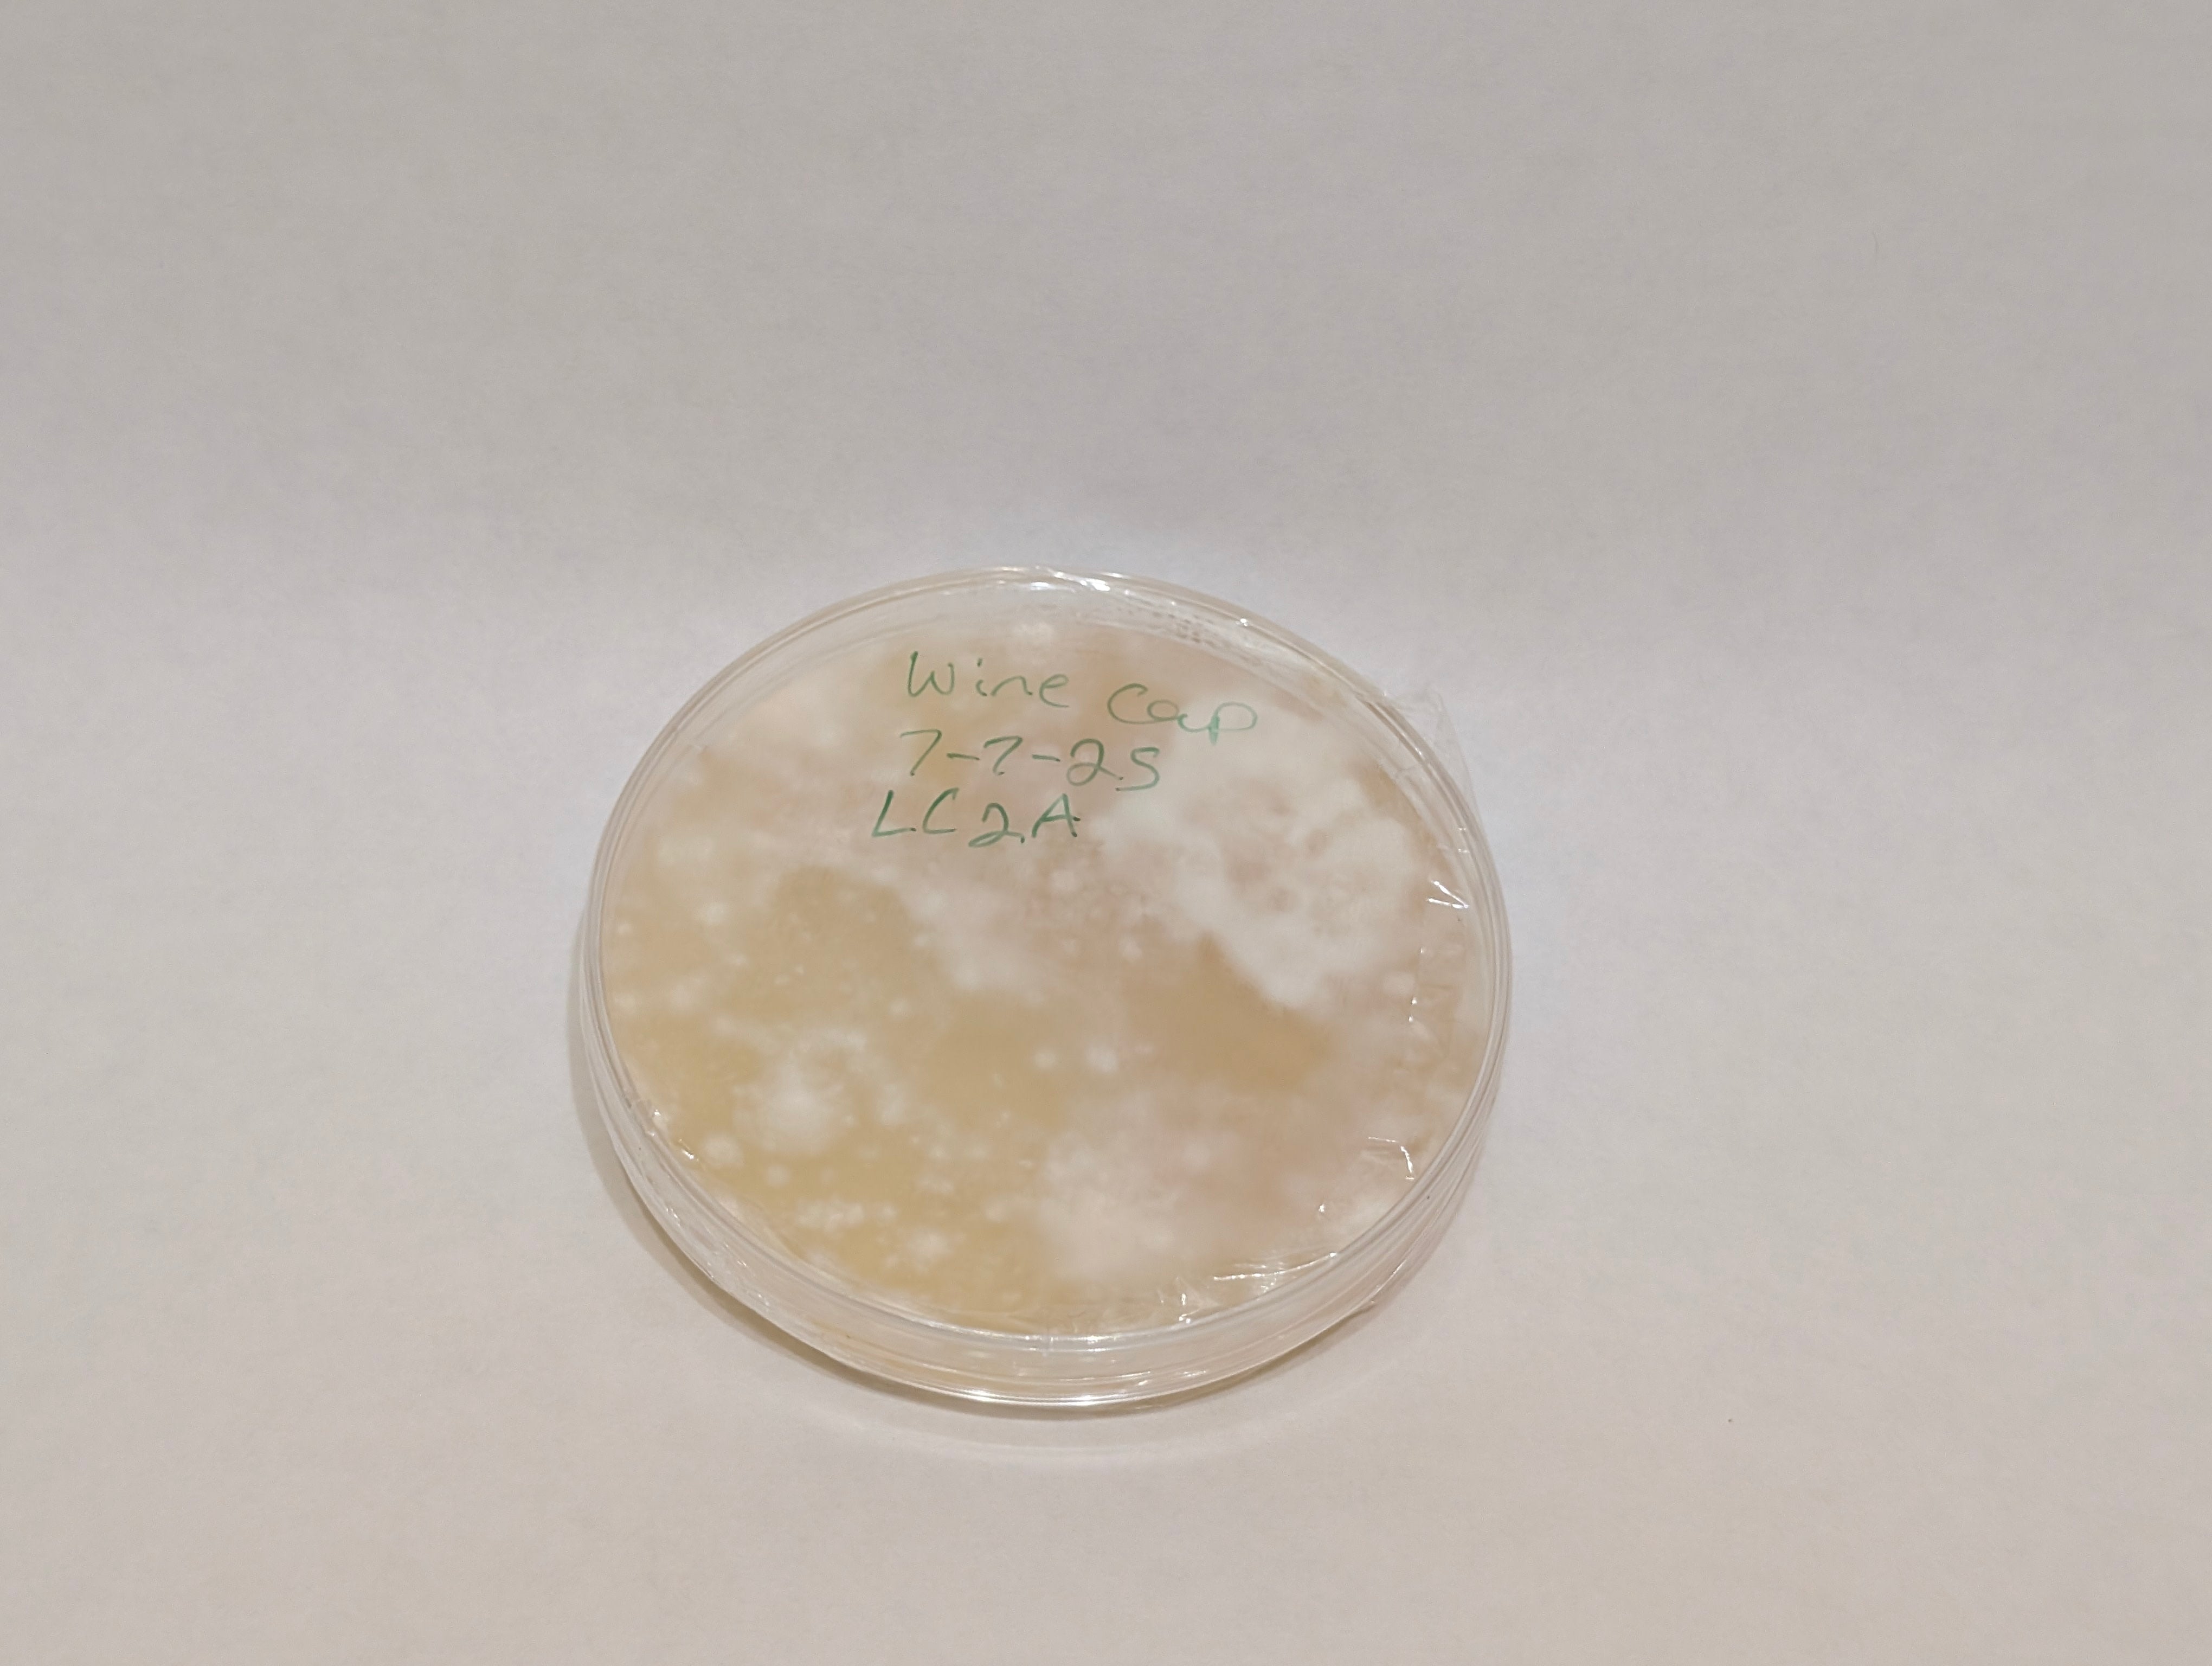

Vendor: My Store
Type:
Price:
40.00
Preserve your Shiitake (Lentinula edodes) genetics with this lab-prepared genetic bank culture. Each plate is carefully cultivated on nutrient-rich agar to maintain a clean, stable strain, ideal for long-term storage, research, or repeated cultivation.
Shiitake is a gourmet and medicinal mushroom prized for its flavor and health benefits. Maintaining a genetic bank ensures you always have access to a reliable, high-quality strain for consistent results.
What You Get:
-
1x Shiitake genetic bank agar plate
-
Sterile, lab-prepared culture
-
Long-term preservation for repeated cultivation or research
Why Choose a Genetic Bank?
-
Reliable strain preservation
-
Ideal for hobbyists, researchers, and medicinal growers
-
Maintains clean, stable genetics for future projects
Whether you’re a home grower, mycology researcher, or gourmet mushroom enthusiast, this Shiitake Genetic Bank ensures your strain remains pure, healthy, and ready for cultivation.